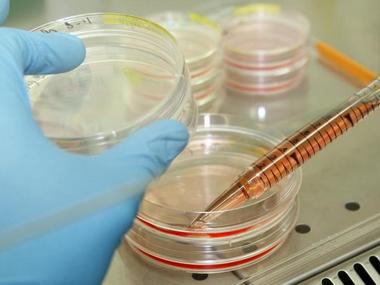
Indian-origin scientist develops artificial bone tissues, may help simplify transplant procedure Indian-origin scientist develops artificial bone tissues, may help simplify transplant procedure

Los Angeles: Scientists, led by an Indian-origin researcher, have developed artificial bone tissues that could provide new bone marrow for patients needing transplants and make the procedure much safer.
Researchers led by professor Shyni Varghese from the University of California, San Diego in the United States developed bone tissues with functional bone marrow that can be filled with donor cells and implanted under the skin of mice.
The donor cells survived for at least six months and supplied the mice with new blood cells.
“We have made an accessory bone that can separately accommodate donor cells. This way, we can keep the host cells and bypass irradiation,” Varghese said.
Bone marrow transplants are used to treat patients with bone marrow disease.
Before a transplant, a patient is first given doses of radiation, sometimes in combination with drugs, to kill off any existing stem cells in the patient’s bone marrow.
This pre-treatment is meant to improve success of the transplant by clearing up space in the marrow, allowing donor cells to survive and grow without competition from the patient’s own cells.
However, this treatment often comes with harmful side effects, such as nausea, fatigue, loss of fertility and others.
To address these issues, researchers developed a bone-like implant that gives donor cells their own space to live and grow without competition, eliminating the need to wipe out the host’s pre-existing cells.
“In the future, our work could contribute to improved therapies for bone marrow disease,” said Yu-Ru Shih, a research scientist in Varghese’s lab and the first author of the study published in the journal PNAS.
Varghese said that these implants would be limited to patients with non-malignant bone marrow diseases, where there are not any cancerous cells that need to be eliminated.
The implants mimic the structure of long bones in the body, consisting of an outer bone compartment and an inner marrow compartment.
The implants are made of a porous hydrogel matrix. The outer matrix contains calcium phosphate minerals. Stem cells grown in this mineralised matrix differentiate into bone- building cells.
The inner matrix houses donor stem cells that produce blood cells.
When implanted beneath the skin of mice, the structures matured into bone tissues that have a working blood vessel network and a bone marrow inside that supplies new blood cells.
After four weeks, researchers found that the implanted marrow contained a mix of host and donor blood cells. They also found this mix circulating in the bloodstream of these mice even after 24 weeks.
)
)
)
)
)